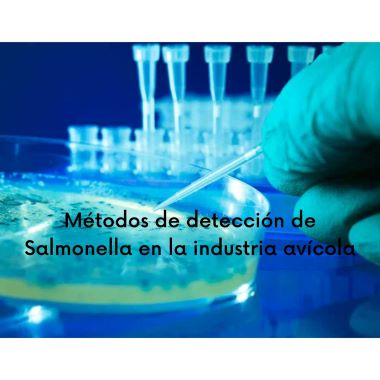

La presentación de Salmonella puede ser devastadora para la industria avícola. Por lo cual, cualquiera que sea la estrategia de intervención para el control, reducción o erradicación, el esfuerzo debe comenzar siempre por la detección de la Salmonella.
Acceder al artículo en https://avinews.com/como-detectar-la-salmonella-en-industria-avicola/
TAGS: Salmonella. Avicultura. Producción avícola. Salmonellosis

No hay comentarios aún.